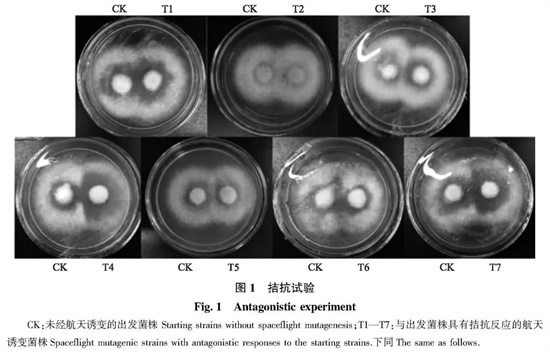

航天诱变育种对金针菇遗传和药用品质性状的影响
林艺美,赖亮民,钟武杰,黄舒婷,王家佩,王杰*
(华南农业大学食品学院,广东 广州 510642)
收稿日期:2023-05-05
基金项目:广东省重点领域研发计划资助项目(2018B020206001); 广东省乡村振兴战略专项资金(20210722); 广东省农业厅种业振兴项目(2022-WPY-00-004)
*通信作者:王杰,教授,博导,主要从事食药用菌生物工程研究,E-mail:wjcasey@scau.edu.cn。
[目的]本文旨在利用航天诱变技术,选育获得金针菇特色优质种质资源。[方法]对金针菇菌株F3-1进行航天诱变处理,通过拮抗试验、分子标记试验和活性物质测定等对航天诱变菌株进行筛选鉴定及遗传变异多样性分析,并筛选活性物质含量高的菌株。[结果]拮抗试验初筛获得7株与出发菌株存在拮抗现象的变异株。分子标记(ISSR、RAPD、SRAP)聚类分析结果表明,7个诱变菌株与出发菌株的遗传相似系数为0.694~0.962,且在遗传相似系数为0.800时可分为3个类群。诱变菌株与出发菌株的菌丝生长速度、生物量、总酚、类黄酮、多糖和麦角硫因等指标的变异系数为7.68%~38.97%,遗传多样性指数H'为1.53~2.00。其中,多糖含量的变异系数最高,受诱变影响大; 总酚的遗传多样性指数最大,诱变类型丰富。生物学特性聚类分析显示,在遗传距离为3.16时分为3个类群。最终筛选获得2株活性物质含量高的菌株(T2和T5),其中T2菌株生长速度、生物量和活性物质等均优于出发菌株,而T5菌株主要表现为高多糖含量菌株,其多糖含量比出发菌株提高114.70%(P<0.01)。[结论]航天诱变处理的金针菇菌株存在丰富的遗传变异多样性,是新品种选育的优异种质资源。
关键词:金针菇; 航天育种; 分子标记; 药用品质性状; 遗传多样性
Effects of spaceflight mutagenesis breeding on genetic and medicinal quality traits of Flammulina filiformis
LIN Yimei,LAI Liangmin,ZHONG Wujie,HUANG Shuting,WANG Jiapei,WANG Jie*
(College of Food Science, South China Agricultural University, Guangzhou 510642, China)
[Objectives]This article aimed to obtain characteristics and high-quality germplasm resources of Flammulina filiformis by space mutagenesis technology. [Methods]F.filiformis strain F3-1 was subjected to aerospace mutagenesis. Spaceflight mutagenesis strains were screened, characterized and analyzed for diversity of genetic variations by experiments such as antagonistic experiments, molecular marker experiments and determination of active substances. Strains with high contents of active substances were screened. [Results]Seven variants with obvious antagonism to the starting strain were obtained by antagonism test. Molecular marker(ISSR, RAPD, SRAP)clustering analysis showed that the seven mutant strains and starting strain shared genetic similarity coefficients from 0.694 to 0.962, and could be classified into three clusters at a genetic similarity coefficient of 0.800. The variation coefficients such as mycelial growth rate, biomass, phenolics, flavanoid, polysaccharide and ergothionein between mutagenized and starting strains ranged from 7.68% to 38.97%, and the genetic diversity index H' ranged from 1.53 to 2.00. Among them, the highest coefficient of variation was found for polysaccharide content, indicating that it was greatly affected by mutagenesis; the genetic diversity index was largest for total phenols, indicating its rich mutagenesis types. Biological properties cluster analysis revealed three clusters at a genetic distance of 3.16. Finally, two high polysaccharide content strains(T2 and T5)were obtained by screening, among which T2 was superior to the starting strain in terms of growth rate, biomass and active substances, while T5 was mainly characterized as a high polysaccharide content strain with 114.70% higher polysaccharide content than the starting strain(P<0.01). [Conclusions]There was abundant genetic variation diversity in the strains treated by spaceflight mutagenesis, which was an excellent germplasm resource for new variety breeding.
Keywords:Flammulina filiformis; spaceflight breeding; molecular marker; medicinal quality traits; genetic diversity
引言
金针菇(Flammulina filiformis),别名冬菇、朴菇等,其菌盖滑嫩、菌柄细长脆嫩,形美,味鲜,具有较高的营养价值[1]; 其富含活性物质如多糖、总酚、类黄酮、麦角硫因等,已被证实具有抗氧化、抗炎、抗肿瘤、降血糖、降血脂等药用作用[2-7],具有一定的药用价值。金针菇是目前最广泛食用的菌类之一,也是我国食用菌生产的常规主品种之一,2020年年产量达227.91万t[8]。然而,我国现有的金针菇种质资源匮乏,工厂化生产所用的菌种主要依赖国外品种,缺乏自主知识产权的优良品种[9]。目前,有些国家的金针菇品种已细化为食用菌种和药用菌种,其育种方向也不断向菌物药方向延伸[10]; 我国对于高营养和药用价值的金针菇新品种的育种研究较少,限制了其深加工行业的发展。随着金针菇市场需求的快速增长,金针菇产业对优良种源的需求更加迫切。
航天育种的原理为通过航天搭载,利用太空环境的特殊诱变作用(太空微重力和辐射等复合作用)使菌种发生遗传变异,再通过地面选育可获得新品种[11-12]。航天育种具有诱变频率高、变异类型丰富,育种周期短,能快速打破基因连锁、促进优异基因聚合等特点,能创造传统杂交育种无法短期得到的新的优良品种,是一种高效的育种技术[13-15]。目前,金针菇的航天诱变育种研究主要集中在耐高温和早熟性特性上[16],尚未关注分子水平和生物学特性的遗传多样性; 且金针菇的育种方向主要集中于高产、抗病、广温等优良菌株的筛选[17],缺少对高活性物质含量菌株的选育研究。
本研究拟对金针菇菌丝体进行航天诱变处理,以拮抗反应为指标初步筛选变异株,利用ISSR、RAPD、SRAP等分子标记进行菌株之间的遗传变异分析。通过测定出发菌株与诱变菌株的生长速度、生物量、活性物质含量等,分析其药用品质性状的遗传多样性,以期揭示航天诱变处理对金针菇菌株药用品质性状的影响,同时对高活性物质含量菌株进行筛选。研究结果可为优质特色金针菇新品种的选育提供参考依据。
1 材料与方法
1.1 材料与试剂
金针菇菌株F3-1,购于广东省微生物研究所菌种保藏中心。ISSR引物、RAPD引物和SRAP引物均由上海生工生物工程股份有限公司合成。San Taq Plus PCR Mix试剂盒购于上海生工生物工程股份有限公司。PDA培养基:马铃薯200 g,蔗糖20 g,琼脂粉20 g,水1 L,pH自然,121 ℃灭菌20 min。
1.2 仪器与设备
Avanti J-E超高速冷冻离心机购于BECKMAN COULTER公司; Fastwin BIS-168凝胶成像系统购于Fastwin Bio-tech公司; T-1 Biometra热密闭PCR仪购于德国Biometra公司; Waters高效液相色谱仪购于沃特世科技有限公司。
1.3 试验方法
1.3.1 菌株航天诱变处理
取试管母种接入PDA培养基,25 ℃培养,连续活化培养3代。取活化后的金针菇菌块于无菌条件下装入冻存管,搭载长征五号B运载火箭进入太空进行航天诱变处理。
1.3.2 航天诱变菌株活化
刮取冻存管中金针菇菌块上的菌丝于10 mL无菌水中,加入玻璃珠混匀打碎,稀释10倍,并采用倾注法接至PDA培养基,25 ℃培养。挑取46个航天诱变处理组金针菇单菌落,连续培养3代使性状稳定,进行后续筛选和分析。
1.3.3 拮抗试验筛选
使用打孔器取大小一致的航天诱变处理组金针菇菌块和出发菌株CK组金针菇菌块接至同一平板,菌块相距2 cm,25 ℃下对峙培养,观察是否出现拮抗现象,初步筛选变异株。
1.3.4 分子标记鉴定
参照王艳[18]的DNA提取方法提取金针菇菌株基因组DNA。采用San Taq Plus PCR Mix试剂盒,以金针菇基因组DNA为模板,以4个ISSR引物、3个RAPD引物和5个SRAP引物进行PCR扩增,PCR产物经10 g·L-1琼脂糖凝胶电泳,并使用凝胶成像系统进行观察记录,用于分子标记的遗传多样性分析。
ISSR引物序列(I2、I12、I13、I18)、RAPD引物序列(JS6、JS9、JS15)、SRAP引物序列(Me2-Em8、Me2-Em2、Me3-Em72、Me4-Em2、Me5-Em72)见表1。ISSR和RAPD扩增反应程序:94 ℃ 5 min; 94 ℃ 30 s,50 ℃ 30 s,72 ℃ 1~2 min,循环35次; 72 ℃延伸10 min。SRAP扩增反应程序:94 ℃ 5 min; 94 ℃ 1 min,35 ℃ 1 min,72 ℃ 1 min,5个循环; 然后94 ℃ 1 min,50 ℃ 1 min,72 ℃ 1 min,循环30次; 72 ℃延伸10 min。
表1 引物序列
Table 1 Primer sequence

1.3.5 药用品质性状测定
使用打孔器打取相同数量的直径8 mm的金针菇出发菌株及诱变菌株菌块,接入100 mL PDB培养基,25 ℃、180 r·min-1条件下培养7 d,用于生物量、总酚、类黄酮、多糖、和麦角硫因等指标的测定。采用十字交叉法测定菌丝生长速度,将通过拮抗试验筛选的菌株打孔接至PDA培养基,25 ℃培养,菌丝萌发后在菌丝边缘标记起始点位,培养完成后标记终止点位,菌丝生长速度用菌落直径的增长值与时间的比值表示。使用抽滤装置将振荡培养7 d的金针菇菌丝过滤,将过滤后的菌丝球用蒸馏水冲洗数次,置于60 ℃烘箱烘干至恒重,称重并记录,计算菌丝生物量。
采用Folin-Ciocalteu法测定胞内总酚含量。取金针菇菌丝,加入80%乙醇充分研磨,70 ℃水浴浸提,选用没食子酸为总酚测定标准品进行测定。采用NaNO2-Al(NO3)3-NaOH法测定胞内类黄酮含量。提取方法同测定总酚含量的方法,选用芦丁标准液为类黄酮测定标准品,类黄酮的量表示为每克提取物的芦丁毫克当量。采用苯酚-硫酸法测定胞内多糖含量。取金针菇菌丝,加入95%乙醇进行超声(1 000 Hz)提取加热回流2 h,趁热过滤,即得多糖提取液,选用葡萄糖为多糖测定标准品进行测定。采用莫宇丽等[19]的方法提取并测定胞内麦角硫因含量。
1.4 数据统计与分析
根据ISSR、RAPD、SRAP的电泳结果,多态性条带被记为“1”,非多态性条带被记为“0”,以此产生“0-1”矩阵,使用NTSYS软件系统,采用UPGMA进行聚类分析,以Dice系数生成ISSR、RAPD、SRAP的遗传相似性矩阵和综合聚类图。
对生长速度、生物量、总酚含量、类黄酮含量、多糖含量及麦角硫因含量等进行差异分析、变异分析与遗传多样性分析、聚类分析。变异系数=(标准偏差/平均值)×100%。将药用品质性状结果进行4个等级的划分:1级≤x-0.5σ,4级>x+0.5σ,每0.5σ为1级,σ为标准差,x为平均值。根据药用品质性状结果的分级赋值,使用Excel 2016软件根据公式计算出其遗传多样性指数。遗传多样性指数计算采用Shannon-Weaver信息指数(H'),H'=-∑Piln Pi(i=1,2,…,n),其中Pi指某药用品质性状第i个级别占总数的比例。将药用品质性状数据作标准化转换,采用UPGMA进行聚类分析,以欧氏距离生成药用品质性状的遗传距离矩阵和综合聚类图。
2 结果与分析
2.1 诱变菌株的体细胞亲和性试验
通过拮抗试验筛选得到7个与出发菌株具有拮抗反应的航天诱变菌株,结果如图1所示。T1、T4、T6和T7菌株与出发菌株CK有拮抗现象,但无明显拮抗线,即菌株间有弱拮抗; T2、T3和T5菌株与出发菌株CK之间有气生菌丝隆起的现象,菌株间拮抗作用明显。可初步判断7个金针菇航天诱变菌株与出发菌株存在不同程度的体细胞不亲和性。
图1 拮抗试验
Fig.1 Antagonistic experiment
2.2 诱变菌株的分子标记鉴定分析
2.2.1 ISSR、RAPD、SRAP多态性分析
ISSR、RAPD和SRAP分子标记试验显示,7个航天诱变菌株与出发菌株间存在多个变异位点。通过ISSR-PCR电泳图谱(图2)筛选出3条多态性较高、谱带清晰、重复性好的ISSR引物(I12、I13、I18),扩增的总谱带数为12条,其中7条具有多态性,多态性比率为58.33%。RAPD-PCR电泳图谱(图3)显示3个RAPD引物(JS6、JS9、JS15)均能扩增出清晰的谱带,表现出良好的多态性,可用于验证试验,扩增的总谱带数为10条,均具有多态性,多态性比率为100%。对5个SRAP引物进行筛选,试验获得共计3个SRAP引物(Me2-Em8、Me3-Em72、Me5-Em72)可用于验证试验,3个引物可获得清晰可辨的位点及多态性位点,扩增的总谱带数为16条,其中8条具有多态性,多态性比率为50%,扩增产物电泳图如图4所示。

图2 ISSR-PCR电泳图谱
Fig.2 Electropherogram of ISSR-PCR

图3 RAPD-PCR电泳图谱
Fig.3 Electropherogram of RAPD-PCR

图4 SRAP-PCR电泳图谱
Fig.4 Electropherogram of SRAP-PCR
2.2.2 ISSR、RAPD、SRAP的遗传相似性矩阵和综合聚类分析
由表2和图5可以看出,每个菌株之间的遗传距离都不为0,且拥有直系同源基因; 8个菌株遗传相似系数为0.694~0.962,说明彼此有一定的遗传差异,不属于同一株,表明7个诱变菌株发生了不同程度的变异。同时,综合聚类分析图(图5)显示,在遗传相似系数为0.800时,8个菌株被分为3个类群:出发菌株CK、T1聚为第Ⅰ类,T6、T7聚为第Ⅱ类,T2、T3、T4、T5聚为第Ⅲ类; 第Ⅲ类在相似系数为0.880时分为2个亚类,T2、T3、T5聚为第1个亚类,T4为第2个亚类。其中,遗传相似性矩阵(表2)显示,T3和T5的遗传相似系数最高,达0.962,有着紧密的亲缘关系; 而T4和T7的遗传相似系数最低,为0.694,即T4和T7间的亲缘关系最远。

表2 ISSR、RAPD和SRAP遗传相似性矩阵
Table 2 Genetic similarity matrix of ISSR,RAPD and SRAP

图5 ISSR、RAPD和SRAP综合聚类
Fig.5 Dendrogram of ISSR,RAPD and SRAP
2.3 药用品质性状变化分析
2.3.1 菌丝生长速度与产活性物质能力的差异性分析
由表3可知,金针菇航天诱变菌株菌丝与出发菌株菌丝间的生长速度与产活性物质能力差异明显。T2菌株的菌丝生长速度极显著高于其他菌株,比出发菌株提高30.99%; 除T4外,其余6株航天诱变菌株的生物量均极显著高于出发菌株,T6生物量最高,比出发菌株提高21.46%; 7株航天诱变菌株的总酚含量与出发菌株没有极显著的差异; T2、T3、T4、T5和T7菌株的类黄酮含量均极显著高于出发菌株,其中T3的类黄酮含量比出发菌株提高97.80%; T2和T5菌株的多糖含量均极显著高于出发菌株,T5的多糖含量最高,比出发菌株提高114.70%; T2菌株麦角硫因含量极显著高于出发菌株,比出发菌株提高11.96%。

表3 菌丝生长速度与产活性物质能力差异性分析
Table 3 Analysis of differences in mycelial growth rate and ability to produce active substances
2.3.2 产活性物质能力的变异分析与H'分析
金针菇航天诱变菌株菌丝与出发菌株菌丝间的产活性物质能力的变异分析与H'分析见表4。结果显示,诱变菌株和出发菌株的菌丝变异较大,变异系数的变幅为7.68%~38.97%,变异系数差异明显,其变异系数由小到大依次为多糖、类黄酮、麦角硫因、生物量、总酚。变异系数大于20%的有多糖、类黄酮,表明其受航天诱变影响较大,以多糖变异系数最高,诱变影响最突出; 生物量和总酚的变异系数小于10%,说明其受诱变影响不明显,变异较小。遗传多样性指数H'为1.53~2.00,总酚的遗传多样性指数最高,即总酚的变异类型更丰富。
表4 产活性物质能力的变异分析与遗传多样性指数H'分析
Table 4 Analysis of variation and genetic diversity index H' of the ability to produce active substances

2.3.3 突变菌株性状遗传距离矩阵和综合聚类分析
各菌株生物学特性的遗传距离见表5,遗传距离变幅为1.418 6~4.751 2。7株诱变菌株与CK的遗传距离均不为0,说明其与出发菌株存在表型差异。通过聚类分析,在遗传距离为3.16处将出发菌株和诱变菌株聚为3个类群,见图6。第Ⅰ类群包括T2和T5,该类群中的菌株均含有高含量的总酚、类黄酮、多糖和麦角硫因; 第Ⅱ类群包括T3和T4,该类群中的菌株含有高含量的类黄酮,但麦角硫因的含量较低; 第Ⅲ类群包括CK、T1、T6和T7,其生长速度、类黄酮含量和多糖含量较低。
表5 突变菌株性状遗传距离矩阵
Table 5 Genetic distance matrix of mutant strain traits


图6 突变菌株性状的综合聚类
Fig.6 Dendrogram of mutant strain traits
3 讨论
航天诱变会对生物材料的组织、细胞结构、生理代谢途径及遗传物质产生影响。本研究利用该特点对金针菇菌丝进行航天诱变处理,以期获得优质特色金针菇新品种。
拮抗反应目前作为一种鉴定菌株遗传差异的传统方法广泛用于丝状真菌种内菌株的鉴定和分类。本研究通过拮抗试验发现7个航天菌株与出发菌株出现强弱不定的拮抗现象,说明7个航天菌株与出发菌株存在不同程度的不亲和性。
ISSR、RAPD、SRAP等分子标记可从DNA水平反映菌株间的遗传差异,常用于进行菌株间亲缘关系及遗传多样性研究。何法慧等[20]应用SSR和SRAP等技术揭示狗牙根不同种质材料间存在遗传差异; 赵丽丽等[21]利用ISSR标记揭示辐射诱变白刺花可导致后代中产生丰富的遗传多样性; 李艳丽等[22]通过RAPD标记发现紫外线诱变刺芹侧耳菌株与亲株有显著的遗传差异,暗示其为一株新的刺芹侧耳变异菌株。本研究基于ISSR、RAPD、SRAP引物扩增出的图谱结果进行遗传多样性和聚类分析,结果显示7个航天诱变菌株和出发菌株的遗传相似系数为0.694~0.962,诱变菌株和出发菌株被聚为3类,表明诱变菌株与出发菌株间具有亲缘关系,但存在遗传差异,判断诱变菌株为新的金针菇变异菌株,且诱变菌株在分子水平上具有丰富的遗传多样性。
遗传物质的变化往往会影响生物体的性状变化。本研究发现本次航天诱变金针菇菌丝对其药用品质性状产生明显影响。研究发现,多糖和类黄酮的变异系数较高,总酚的H'值最高。在选育新品种的过程中,变异系数和H'值越大,表明遗传多样性越丰富。因此,本次金针菇的航天诱变菌株的活性物质存在丰富的遗传多样性,有利于丰富金针菇的种质资源。遗传聚类发现T2、T5菌株与其他菌株的遗传距离较远,且其活性物质含量较高。与出发菌株相比,T2菌株的生长速度、生物量、类黄酮含量、多糖含量、麦角硫因含量分别提高30.99%、10.32%、37.17%、60.74%、11.96%,是金针菇高活性成分生产菌种的潜力菌株。而T5菌株多糖含量高,比出发菌株提高114.70%。航天诱变对决明[23]、夏枯草[24]、柴胡[25]等活性物质具有显著影响,且大多存在正向影响。本研究利用航天诱变获得2株具有高活性物质的金针菇菌株,可为金针菇深加工产业提供优质的种质资源,为优质特色金针菇新品种的选育提供参考依据。
参考文献
[1]王翠翠,崔成伟,陈屏,等. 金针菇化学成分及药理活性研究进展[J]. 菌物研究,2021,19(3):207-216.
Wang C C,Cui C W,Chen P,et al. Research advances on chemical constituents and pharmacological activities of Flammulina filiformis[J]. Journal of Fungal Research,2021,19(3):207-216(in Chinese with English abstract).
[2]Yeh M Y,Ko W C,Lin L Y. Hypolipidemic and antioxidant activity of enoki mushrooms(Flammulina velutipes)[J]. Biomed Res Int,2014,2014:352385.
[3]Zhang T,Ye J,Xue C,et al. Structural characteristics and bioactive properties of a novel polysaccharide from Flammulina velutipes[J]. Carbohydr Polym,2018,197:147-156.
[4]Hu Q,Yu J,Yang W,et al. Identification of flavonoids from Flammulina velutipes and its neuroprotective effect on pheochromocytoma-12 cells[J]. Food Chem,2016,204:274-282.
[5]李杨,王锋,朱金锦,等. 灵芝全麦菌粮菌种筛选及抗氧化能力评价[J]. 沈阳农业大学学报,2022,53(4):423-431.
Li Y,Wang F,Zhu J J,et al. Strain screening and antioxidant capacity evaluation of Ganoderma lucidum whole wheat fungus grain[J]. Journal of Shenyang Agricultural University,2022,53(4):423-431(in Chinese with English abstract).
[6]Ma S,Xu J,Lai T,et al. Inhibitory effect of fermented Flammulina velutipes polysaccharides on mice intestinal inflammation[J]. Front Nutr,2022,9:934073.
[7]Ma S,Zhang H,Xu J. Characterization,antioxidant and anti-inflammation capacities of fermented Flammulina velutipes polyphenols[J]. Molecules,2021,26(20):6205.
[8]中国食用菌协会. 2020年度全国食用菌统计调查结果分析[J]. 中国食用菌,2022,41(1):85-91.
China Edible Fungi Association. Analysis of the results of the national edible fungi statistical survey in 2020[J]. Edible Fungi of China,2022,41(1):85-91(in Chinese).
[9]刘启燕,戚俊,王卓仁,等. 我国金针菇工厂化生产现状与思考[J]. 中国食用菌,2021,40(12):83-88.
Liu Q Y,Qi J,Wang Z R,et al. Current situation and thinking of Flammulina filiformis in industrialized production in China[J]. Edible Fungi of China,2021,40(12):83-88(in Chinese with English abstract).
[10]张清洋,白雪霏,朱姝蕊,等. 日本金针菇品种权研究[J]. 食药用菌,2020,28(4):241-247.
Zhang Q Y,Bai X F,Zhu S R,et al. Study on the variety rights of Flammulina velutipes in Japan[J]. Edible and Medicinal Mushrooms,2020,28(4):241-247(in Chinese).
[11]Luxton J J,McKenna M J,Lewis A,et al. Telomere length dynamics and DNA damage responses associated with long-duration spaceflight[J]. Cell Rep,2020,33(10):108457.
[12]Xiong H,Guo H,Xie Y,et al. RNAseq analysis reveals pathways and candidate genes associated with salinity tolerance in a spaceflight-induced wheat mutant[J]. Scientific Reports,2017,7:2731.
[13]Mohanta T K,Mishra A K,Mohanta Y K,et al. Space breeding:the next-generation crops[J]. Front Plant Sci,2021,12:771985.
[14]Prasad B,Richter P,Vadakedath N,et al. How the space environment influences organisms:an astrobiological perspective and review[J]. International Journal of Astrobiology,2021,20(2):159-177.
[15]Shao Y,Xie C,Jiang L,et al. Discrimination of tomatoes bred by spaceflight mutagenesis using visible/near infrared spectroscopy and chemometrics[J]. Spectrochimica Acta Part A:Molecular and Biomolecular Spectroscopy,2015,140:431-436.
[16]周庆红,杨寅桂,范淑英,等. 金针菇航天种菌丝诱变效应的研究[J]. 中国食用菌,2010,29(5):37-39.
Zhou Q H,Yang Y J,Fan S Y,et al. Studies on space mutating effects of mycelia of Flammulina velutipes(Fr.)Sing[J]. Edible Fungi of China,2010,29(5):37-39(in Chinese with English abstract).
[17]刘昆昂,刘萌,张根伟,等. 金针菇遗传育种研究进展[J]. 江苏农业科学,2019,47(14):18-22.
Liu K A,Liu M,Zhang G W,et al. Research progress in genetics and breeding of Flammulina velutipes[J]. Jiangsu Agricultural Sciences,2019,47(14):18-22(in Chinese).
[18]王艳. 杏鲍菇采后木质化的主要诱因及PePAL2和Pe4CL3的转录调控初探[D]. 广州:华南农业大学,2019.
Wang Y. The main factors inducing postharvest lignification in Pleurotus eryngii and preliminary study on the transcriptional regulation of PePAL2 and Pe4CL3[D]. Guangzhou:South China Agricultural University,2019(in Chinese with English abstract).
[19]莫宇丽,张怡馨,王艳,等. 金针菇中麦角硫因的分离纯化工艺优化[J]. 食用菌,2018,40(5):64-67.
Mo Y L,Zhang Y X,Wang Y,et al. Optimization of separation and purification process of ergothionine from Flammulina velutipes[J]. Edible Fungi,2018,40(5):64-67(in Chinese).
[20]何法慧,左倩倩,于景金,等. 35份狗牙根种质材料指纹图谱构建及染色体倍性鉴定[J]. 南京农业大学学报,2023,46(1):42-54. DOI:10.7685/jnau.202201035.
He F H,Zuo Q Q,Yu J J,et al. Fingerprint construction and chromosome ploidy identification of 35 germplasms in bermudagrass[J]. Journal of Nanjing Agricultural University,2023,46(1):42-54(in Chinese with English abstract).
[21]赵丽丽,王普昶,张宇君,等. 白刺花辐射诱变M2代突变群体的形态特征比较和ISSR分析[J]. 农业生物技术学报,2018,26(10):1698-1706.
Zhao L L,Wang P X,Zhang Y J,et al. Morphological characters and ISSR analyses of M2 generation of the Sophora davidii mutants induced by radiation[J]. Journal of Agricultural Biotechnology,2018,26(10):1698-1706(in Chinese with English abstract).
[22]李艳丽,金周雨,李玉. 原生质体紫外诱变筛选刺芹侧耳高EPS含量菌株及其鉴定[J]. 中国农机化学报,2016,37(12):98-102.
Li Y L,Jin Z Y,Li Y. Screening and identifying strains with high EPS content of Pleurotus eryngii by UV induced protoplast mutagenesis[J]. Journal of Chinese Agricultural Mechanization,2016,37(12):98-102(in Chinese with English abstract).
[23]徐世浩. 航空诱变决明SP7-SP8代良种选育及多点评价[D]. 杨凌:西北农林科技大学,2021.
Xu S H. Selection and multi-point evaluation of good seeds from SP7-SP8 generation of aerially mutagenized Cassia obtusicassia L.[D]. Yangling:Northwest A&F University,2021(in Chinese with English abstract).
[24]冯国亮. 航天诱变对夏枯草SP_3代生物学性状及有效成分积累的影响[D]. 杨凌:西北农林科技大学,2016.
Feng G L. Spaceflight-induced variation on biological traits and effective components of SP_3 Prunella vulgaris L.[D]. Yangling:Northwest A&F University,2016(in Chinese with English abstract).
[25]彭依晴. 航天诱变柴胡SP 2代优良株系田间筛选及其综合评价研究[D]. 杨凌:西北农林科技大学,2022.
Peng Y Q. Study on field screening and comprehensive evaluation of excellent strains of SP_2 generation of space Bupleuri radix[D]. Yangling:Northwest A&F University,2022(in Chinese with English abstract).
来源:《南京农业大学学报》 作者:林艺美, 赖亮民, 钟武杰, 黄舒婷, 王家佩, 王杰













